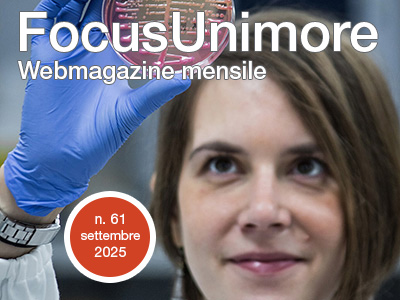

Online il nuovo numero di FocusUnimore
FocusUnimore, il webmagazine dellAteneo di Modena e Reggio Emilia, si apre con leditoriale del Rettore Carlo Adolfo Porro che sottolinea il ruolo dellUniversità come comunità del sapere radicata da ben ottocentocinquantanni nel territorio e connessa ad una rete internazionale di relazioni culturali e scientifiche.
Tra i momenti più significativi dellanno, spicca il conferimento della Laurea Magistrale honoris causa in Giurisprudenza ad Audrey Azoulay, Direttrice Generale dellUNESCO.
Lonorificenza riconosce il suo impegno per la tutela del patrimonio culturale, laccesso alla cultura e una concezione etica dellintelligenza artificiale.
Levento ha visto il suo svolgimento in concomitanza con il XXXIV° Congresso Nazionale della Società Italiana di Filosofia del Diritto che ha riunito a Modena oltre 300 studiosi e studiose provenienti da tutta Italia e da varie parti del mondo.
Lapertura alla cittadinanza dellAteneo si rinnova con la Notte della Ricerca, il 26 settembre a Modena, Reggio Emilia e Mantova, con laboratori, esperimenti, visite guidate, giochi ed eventi interattivi su scienza, sostenibilità, salute, tecnologia e cultura.
Liniziativa si intreccia con la Settimana dellUguaglianza, che propone attività su diritti, stereotipi, parità di genere, cittadinanza digitale e violenza di genere, oltre a mostre e giochi educativi.
Anche il Sistema Bibliotecario di Unimore partecipa con talk, letture, giochi e la presentazione della nuova Biblioteca Digitale Genderm ⊛ re, contribuendo al dialogo tra ricerca, cultura e società.
Dal 23 settembre, torna anche il ciclo di incontri Caffè Scienza che unisce scienza e divulgazione in unatmosfera informale, affrontando temi molto attuali come DNA, arte, IA, neuroscienze e libero arbitrio.
Unimore avrà un ruolo centrale anche nella decima edizione dello Smart Life Festival (1619 ottobre), dedicato al futuro di Internet e delle connessioni digitali, con eventi su lavoro, giustizia, salute, tecnologia e umanesimo.
Sul fronte della ricerca, lateneo annuncia lapertura del nuovo FUELab laboratorio di elettronica flessibile e sostenibile e la nascita di Deep Radars Ltd, spin-off innovativo nel settore radar, che trasferisce competenze accademiche alle imprese.
Infine, lOsservatorio sulla Cittadinanza dImpresa, con sede a Reggio Emilia, prosegue nella promozione di un nuovo modello di responsabilità condivisa tra università, imprese e comunità, affrontando temi cruciali come sostenibilità, benessere e innovazione sociale.
Tutti gli articoli del magazine diretto dal Prof. Thomas Casadei, Delegato alla comunicazione e Portavoce di Ateneo sono reperibili su https://www.focus.unimore.it/
Articolo pubblicato da: Ufficio Stampa Unimore - ufficiostampa@unimore.it il 26/09/2025
